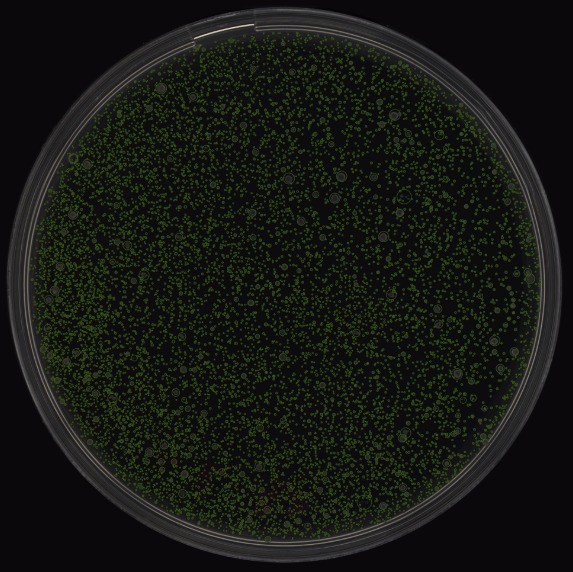

Why Partners Choose Singer
Our customers choose Singer Instruments—and come back to us time and time again—because our values align with their own. Whether we are designing a custom module or manufacturing a full instrument, we live by four simple rules:
✅ Precise: Accuracy is non-negotiable.
✅ Reliable: It must work, every single time.
✅ Delightful to use: User experience is never an afterthought.
✅ Built to last: We engineer for longevity, not obsolescence.
Our Philosophy: Product over hype
We operate on the belief that the best form of marketing is word of mouth. People recommend great products. It’s not that we don’t enjoy marketing; we just prefer to spend our time and effort making kick-ass, reliable products that accelerate scientific research. We let the product experience speak for itself.

Who are Singer Instruments?
Singer Instruments is a unique blend of heritage and high-tech. We are a 3rd generation family business based in the UK, privately owned by Harry Singer and the very people who work here.
This shared-ownership model means that every engineer, designer, and technician you work with is personally invested in the success of your project. We specialise in developing cutting-edge automation workstations, software, and robotics for a global microbial research community.
We are proud to be the trusted partner for some of the world’s most innovative organisations, from leading academic institutions to global technology giants.




Our Approach
We understand that every partner operates differently. Whether you need an agile extension of your R&D team or a fixed-contract manufacturing partner, our workflow is designed to deliver precision and reliability.
The Modern Approach: Lean & Collaborative
Best for: R&D, Prototyping & complex product development
Over the years, we have refined our workflow to ensure 100% success rates for our partners. We adopt a Lean Agile methodology, prioritising flexibility, collaboration, and the elimination of waste.
- Cutting the Waste: Too often, products are engineered with complex features that look good on paper but add unnecessary cost and complexity for the end-user. Instead of locking you into a rigid specification at the start, we use an options-based approach. We validate technical hurdles early and only commit to complex features once we have the data to prove they are necessary and viable.
- Iterative Development: We work in short engineering cycles. Rather than disappearing for months and revealing a finished instrument that might miss the mark, we share demonstrable functionality and prototypes with you regularly. This allows you to test, handle, and provide feedback as we build. It ensures the final result is exactly what you need: a resilient, market-ready product.
The Traditional Route: Fixed Cost, Fixed Scope
Best for: Build-to-Print, Mature Designs & Strict Budget Cycles
We understand that for many organisations, budgetary certainty is paramount. If your internal processes require a Fixed Cost, Fixed Scope arrangement, we are fully equipped to deliver it.
How we differ from the industry standard: In traditional engineering projects, unforeseen challenges usually lead to one of two outcomes:
- Inflated Costs: Vendors add massive “buffer margins” to the quote to cover potential risks, charging you for problems that may never happen.
- Sacrificed Quality: When timelines slip, the “testing phase” at the end of the project is squeezed or cut entirely to meet the deadline.

The Singer Advantage
We do not believe quality should be the victim of a fixed budget. Even within a Fixed Scope contract, we utilise our internal Risk-Based Approach. We identify and tackle the highest-risk engineering challenges first, rather than leaving them until the end.
By front-loading the risk, we ensure that:
- Testing is never compromised: Quality Control remains a constant throughout the build, not a rushed afterthought.
- Costs remain fair: Our efficiency allows us to quote competitively without needing excessive financial buffers.
- Delivery is guaranteed: You get the certainty of a fixed price, with the agility and quality assurance of a modern engineering firm.

Our OEM Services
Research & Development (R&D)
Biological & Technical Feasibility. We bridge the gap between “blue sky” thinking and the rigorous realities of the wet lab. Leveraging our in-house bio laboratory, we test concepts against real biological constraints from day one. We don’t just determine if a concept is
mechanically possible; we prove it is biologically viable.

Artificial Intelligence (AI)
Computer Vision & Deep Learning. We bring intelligence to automation. Whether you need colony counting, phenotypic analysis, or complex decision-making, we have the tools ready.
- Pre-Trained Power: Partners can tap into our existing, robust inference engines, trained on millions of data points.
- Custom Pipelines: For unique applications, we utilise our rapid training pipelines to create custom models based on your specific biological data.
- Training Data: Where necessary, we can also generate training data in our laboratory or leverage well-established academic and industrial partnerships.
Software & Firmware
Intelligent Control & Connectivity. Hardware is nothing without the code that drives it. Our in-house software team builds the full stack:
from real-time embedded firmware and precise motor control to intuitive User Interfaces (GUIs). Crucially, we prioritise connectivity, providing open, well-documented APIs for seamless integration with LIMS or Total Lab Automation (TLA) systems.


User Experience (UX)
Design Driven by Scientists. We believe an instrument is only as good as the workflow it supports. We keep real customers in the loop throughout the development process, conducting workflow analysis and usability testing with active scientists. This ensures the final product is intuitive, efficient, and delightful to use.
Design & Engineering
Scale-Appropriate Architecture. Our engineering strategy is grounded in commercial reality. We focus on Design for Manufacture (DfM) for low-to-medium volumes first, prioritising time-to-market and flexibility over high capital constraints. We deliberately reserve deep Value Engineering (VAVE) to reduce Cost of Goods Sold (COGS) until after throughput is proven. This phased approach protects your capital, ensuring you don’t invest in mass-production optimisation until market demand is validated.


Rapid Prototyping
The “Lab-in-the-Loop” Advantage. Speed is essential, but accuracy is paramount. Because we own the full stack of expertise, we achieve incredibly fast iteration cycles. We don’t just 3D print parts; we test sub-assemblies on real biology in our internal lab, allowing us to validate, refine, and perfect designs in record time.
QA/QC & Compliance
Rigorous Validation & Traceability. Our Quality Assurance goes beyond measuring tolerances. We employ rigorous internal standards and traceability protocols for every component. We
design test protocols that replicate real-world usage, ensuring every instrument meets the highest criteria of reliability and performance before it leaves our floor. Specific regulatory requirements? We are experienced in navigating compliance frameworks – let’s discuss your specific needs.


Build-to-Print
Scalable UK Manufacturing. For partners with finalised designs, we offer a seamless manufacturing service. We act as a vertically integrated extension of your business, managing supply chains, assembly, and testing under one roof. You get the security of UK-based manufacturing with the scalability required to meet global demand.
Service & Support
Global Lifecycle Management. Our partnership doesn’t end at the factory door. We offer a flexible support ecosystem designed to scale with you. We can act as your front-line ticketing service, resolving initial queries and evolving documentation in real-time. For complex challenges, we provide a cost-effective escalation pathway, ensuring issues are resolved by the engineers who built the product.
From remote troubleshooting and physical spare parts management to technical training and servicing documentation, we help you keep your fleet running, wherever it is in the world.

Intellectual Property & Security
We understand that your intellectual property is your most valuable asset. Our business is built on long-term trust, and we have robust systems in place to ensure your innovation remains strictly yours.
Total Confidentiality
We operate under strict Non-Disclosure Agreements (NDAs) and Master Services Agreements (MSAs) tailored to your legal requirements. Whether you are a university spin-out or a multinational corporation, we treat your data with the highest classification of sensitivity.
Single-Site Security
The biggest risk to IP is often a fragmented supply chain. At Singer Instruments, we design, code, test, and manufacture under one roof in the UK. We do not outsource your core technology to third-party overseas vendors, eliminating the risk of design leaks or counterfeit manufacturing.
Clear IP Ownership (Background vs. Foreground)
We offer transparent contracts that clearly define ownership, protecting both your specific innovation and our core platform technologies:
- Foreground IP: Any bespoke designs, hardware, or custom algorithms developed specifically for your unique application belong to you.
- Background IP: You benefit from our pre-existing technologies (such as our pre-trained AI inference engines or motor control libraries) via a perpetual license for use within the product. This allows you to leverage our “tried and tested” tech stack without legal ambiguity.
Data Integrity
Our physical and digital infrastructure is ring-fenced. Client data is siloed, access-controlled, and backed by enterprise-grade cyber security protocols to protect your proprietary software and biological data.
Ready to accelerate your product roadmap?
Whether you have a “napkin sketch” concept that needs R&D validation,
or a mature design ready for manufacture, our team is ready to integrate with yours.
Let’s discuss your project.